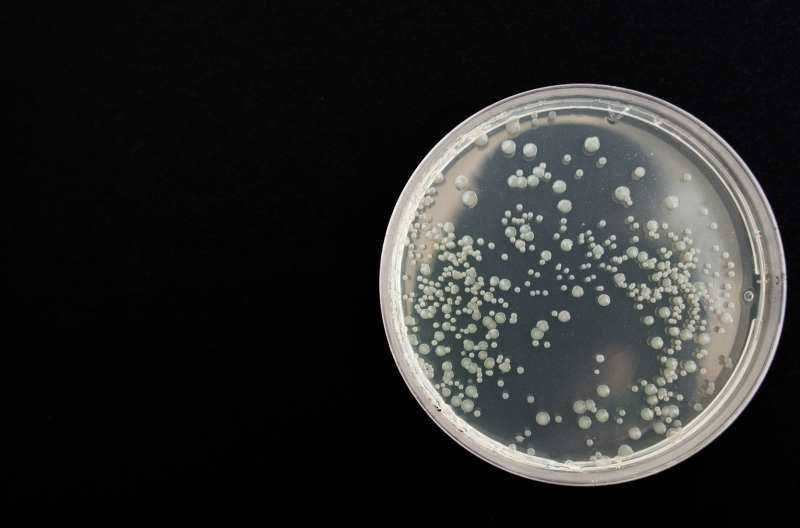

C’est de plus en plus clair: l’abus d’antibiotiques chez les animaux est un danger pour la santé humaine (voir notre reportage Dinde dodue (mais dopée?) ).
En 2003, la majorité des couvoirs du Québec produisant des poulets à griller effectuaient des injections de ceftiofur (un antibiotique) dans les œufs avant leur éclosion pour prévenir les infections à l’ E. coli (pratique par ailleurs interdite aux États-Unis).
Le ceftiofur n’est pas utilisé chez l’homme, mais il s’apparente à la ceftriaxone, un
antibiotique très important en médecine. En réaction aux préoccupations de santé publique, les propriétaires de couvoirs du Québec ont volontairement cessé l’utilisation de ceftiofur en 2006.
Les résultats ont été immédiats: la proportion d’ E. coli résistant au ceftiofur a baissé de 65% à 7% chez les volailles et le taux d’ E. coli résistant au ceftriaxone chez l’humain a parallèlement diminué de 31% à 8%! De quoi confirmer la corrélation entre les résistances observées chez les animaux et celles qui donnent du fil à retordre aux médecins.
Malheureusement, le ceftiofur a été partiellement réintroduit, en 2007, pour des raisons économiques, et le nombre de souches d’ E. coli et de salmonelles résistantes ne cesse d’augmenter depuis.
Plus récemment, en Caroline du Nord, l’équipe de Christopher Heaney, chercheur à la Johns Hopkins Bloomberg School of Public Health, a étudié les staphylocoques dorés








